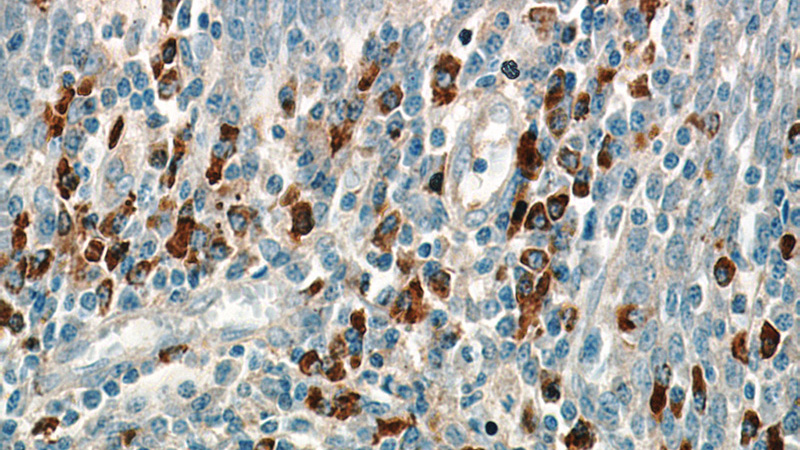
Immunohistochemical of paraffin-embedded human tonsil using Catalog No:107270(IGHA1 antibody) at dilution of 1:50 (under 40x lens)

-
Product Name
Human IgA antibody
- Documents
-
Description
Human IgA Mouse Monoclonal antibody. Positive WB detected in human saliva tissue, human placenta tissue, human plasma tissue. Positive IHC detected in human tonsil tissue, human small intestine tissue. Observed molecular weight by Western-blot: 55-60 kDa
-
Tested applications
ELISA, IHC, WB
-
Species reactivity
Human; other species not tested.
-
Alternative names
FLJ14473 antibody; FLJ35065 antibody; FLJ35500 antibody; FLJ36402 antibody; FLJ39698 antibody; FLJ40001 antibody; FLJ41548 antibody; FLJ41552 antibody; FLJ41789 antibody; FLJ43248 antibody; FLJ43594 antibody; FLJ44293 antibody; FLJ46028 antibody; FLJ46621 antibody; FLJ46724 antibody; FLJ46811 antibody; FLJ46824 antibody; FLJ90170 antibody; IgA1 antibody; IGHA1 antibody
-
Isotype
Mouse IgG1
-
Preparation
This antibody was obtained by immunization of Human IgA recombinant protein (Accession Number: BC016369). Purification method: Caprylic acid/ammonium sulfate precipitation.
-
Clonality
Monoclonal
-
Formulation
PBS with 0.1% sodium azide and 50% glycerol pH 7.3.
-
Storage instructions
Store at -20℃. DO NOT ALIQUOT
-
Applications
Recommended Dilution:
WB: 1:5000-1:50000
IHC: 1:20-1:200
-
Validations

human saliva tissue were subjected to SDS PAGE followed by western blot with Catalog No:107270(Human IgA Antibody) at dilution of 1:16000

Immunohistochemical of paraffin-embedded human tonsil using Catalog No:107270(IGHA1 antibody) at dilution of 1:50 (under 10x lens)
Immunohistochemical of paraffin-embedded human tonsil using Catalog No:107270(IGHA1 antibody) at dilution of 1:50 (under 40x lens)
-
Background
Ig alpha is the major immunoglobulin class in body secretions. It may serve both to defend against local infection and to prevent access of foreign antigens to the general immunologic system. This antibody recognizes the Chain C region of human Ig alpha-1 (IGHA1).
Related Products / Services
Please note: All products are "FOR RESEARCH USE ONLY AND ARE NOT INTENDED FOR DIAGNOSTIC OR THERAPEUTIC USE"
